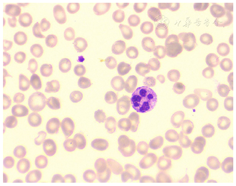

患儿,男性,5岁,因"咳嗽7 d,长期腹泻,发现全血细胞减少1 d"就诊入院。患儿3年前无明显诱因开始出现腹泻,其饮食单一,体重自腹泻以来增长较慢,4岁时入住本院发现CD19+B淋巴细胞比例明显减低,同时免疫球蛋白结果明显减低,结合患儿长期腹泻以及生长发育迟缓,综合考虑为免疫缺陷病,其后行全外显子检测,确诊为X连锁免疫缺陷病,但患儿出院后未再规律注射免疫球蛋白。
一般情况及精神欠佳,面色苍黄,营养不良貌,咳嗽伴咳痰,双肺呼吸音粗糙。体重11.5 kg(<同年龄同性别3 SD)。
CD19+B淋巴细胞比例及免疫球蛋白含量极度减低以及全外显子检查显示其BTK基因发生突变,证实患儿为X连锁无丙种球蛋白血症。患儿外周血全血细胞减少,骨髓提示巨幼细胞贫血以及维生素B12含量减低,故诊断为巨幼细胞贫血。
抗感染治疗,静注人免疫球蛋白补充丙种球蛋白对症,维生素B12肌肉注射。
患儿病情好转,体重增高出院。患儿后期未按时输注丙种球蛋白,血常规3系已恢复正常,但红细胞平均体积提示为小细胞,需考虑缺铁可能。
内分泌科;血液科;检验科
版权归中华医学会所有。本文为遵循CC-BY-NC-ND协议的开放获取文章。
X连锁无丙种球蛋白血症(X-linked agammaglobulinemia,XLA)是儿童原发性免疫缺陷病(primary immunodeficiency disease,PID)最常见的类型之一,它是由于人类Bruton’s酪氨酸激酶(BTK)基因突变,使B细胞发育障碍,从而导致血清免疫球蛋白水平降低或缺失,感染易感性增加的一种原发性体液免疫缺陷病,为原发性B细胞缺陷的典型代表。其中外周血CD19+B淋巴细胞计数显著降低以及血清中各类免疫球蛋白明显降低或缺乏是XLA的典型免疫学特征,对于XLA的早期筛查及诊断有重要的临床价值。对此病应及早进行基因诊断,规律地采用免疫球蛋白进行终身替代治疗可预防及治疗患儿感染、挽救患儿生命。本例XLA患儿由于长期腹泻,同时未进行规律的免疫球蛋白输注治疗,导致全血细胞减少,最终考虑为吸收不良导致的维生素B12缺乏所致的巨幼细胞贫血。临床上部分XLA患儿会合并贫血症状,但合并巨幼细胞贫血的病例报道较少。
患儿,男性,5岁,因"确诊免疫缺陷1年余,咳嗽7 d,发现全血细胞减少1 d"于2021年12月入院。患儿系G1P1早产儿(具体孕周不详),出生体重2.6 kg,现体重10.5 kg(<同年龄同性别3 SD),身高92 cm(<同年龄同性别3 SD)。3年前无明显诱因开始出现腹泻,大便为黄色稀便或淡黄色稀水便,多时5~6次/d,少时2~3次/d,每次量中等,偶见黏液、及泡沫,未见明显脓血及果酱样便,便前便后无哭闹,无呕吐,偶有腹痛,无明显规律,具体部位及持续时间描述不清。因家长自觉"孩子胃肠功能弱",故饮食较为单一,种类多为碳水化合物,蛋白质类饮食较少;病后无特殊治疗;体重自腹泻以来增长较慢。患儿曾在4岁时因"腹泻、体重增长缓慢3年余"于2020年4月收入院,行淋巴细胞亚群检测发现CD19+B淋巴细胞比例明显减低,同时免疫球蛋白结果明显减低,结合患儿长期腹泻以及生长发育迟缓,综合考虑为免疫缺陷病,建议进一步治疗,但患儿父母要求出院转上级医院就诊。2020年5月患儿就诊于外院,行全外显子检测,结果显示X染色体上BTK基因存在一处杂合变异,变异位置处于10号外显子c.894+2_894+3insT,变异来源为母系。2021年12月患儿因3系减少、咳嗽,再次至本院进一步治疗。
既往史:无特殊。个人史、冶游史、手术史:无特殊。家族史:父亲健康,非近期婚配,家族中无遗传病史。母亲为XLA携带者。
体温36.5℃,心率115次/min,呼吸23次/min,体重11.5 kg(<同年龄同性别3 SD),疼痛评分2分,营养异常风险评分5分,压疮风险评分28分,跌倒风险评分13分。一般情况及精神欠佳,神清,面色苍黄,营养不良貌,全身浅表淋巴结未触及肿大,全身皮肤干燥,未见皮疹及皮下出血点,皮下脂肪薄,弹性差,眼窝无凹陷,口唇无干燥,脱水征不显,三凹征(−),浅表淋巴结无肿大,咽充血,颈软无抵抗,胸廓对称无畸形,呼吸节律正常,双肺呼吸音粗糙,未闻及明显干、湿啰音,心音有力,律齐,未闻及心脏杂音。腹软不胀,肝脾未触及,肠鸣音4次/min,双下肢无水肿,肛周无红肿,肢端暖,指、趾端无发绀,神经系统查体未见异常。
2020年5月在外院行全外显子检查,发现其X染色体上BTK基因存在一处杂合变异,变异位置处于10号外显子c.894+2_894+3insT,变异来源为母系。
2021年11月因3系减少、咳嗽入院,血细胞分析:白细胞计数4.42×109/L,中性粒细胞计数0.79×109/L,淋巴细胞计数为3.34×109/L,红细胞计数为1.7×1012/L,血红蛋白60 g/L,平均红细胞体积为108.8 fl,平均红细胞血红蛋白含量为35.9 pg,平均红细胞血红蛋白浓度为330 g/L,血小板计数70×109/L。可见外周血3系减少,贫血分型为大细胞型贫血。
淋巴细胞亚群测定:CD3+ 95.34%,CD3+CD8+ 43.71%,CD3+CD4+ 49.39%,CD4/CD8 1.13,CD16+CD56+ 4.41%,CD19+ 0.04%,CD3+CD4+CD8+ 0.17%。CD19+B淋巴细胞比例明显减低。生化体液免疫检测:IgG为0.95 g/L,IgM 0.02 g/L,IgA 0.10 g/L。免疫球蛋白均减低。维生素B12(化学发光法):139.8 pg/ml,小于参考范围。
骨髓细胞学检查:易见粒系及红系巨幼变,提示符合巨幼细胞贫血骨髓象。其外周血涂片易见大红细胞及卵圆形红细胞,可见6叶核中性分叶粒细胞(图1)。骨髓涂片易见巨杆状核粒细胞、巨晚幼粒粒细胞及巨幼变的幼红细胞(图2)。




消化系统感染性病原体基因检测(25种):粪便标本中检测到病原体空肠弯曲菌,大肠杆菌EPEC菌株。血尿有机酸检查:尿液有机酸检查显示甲基丙二酸及甲基枸橼酸增高,血液有机酸检查显示丙酰肉碱与乙酰肉碱比值增高。2项结果均提示甲基丙二酸血症可能。同型半胱氨酸检测:16.4 μmol/L。生长激素激发实验:生长激素(0、30、60、90 min)1.11、1.31、2.94、3.41、4.43 ng/ml。结果提示生长激素激发水平低,考虑生长激素缺乏。电子胃镜及结肠镜检查未见明显异常。
本例患儿在4岁时因"腹泻、体重增长缓慢3年余"于2020年4月收入院。入院后予小儿复方氨基酸补液、氯化钾补钾、酪酸梭菌二联活菌散补充肠道益生菌、蒙脱石散保护胃肠黏膜、赖氨葡锌补锌治疗,完善电子胃肠镜检查未见明显异常。患儿父母要求出院转上级医院就诊。
2021年12月患儿因3系减少、咳嗽再次入院,经检查发现维生素B12减低及骨髓细胞学结果提示巨幼细胞贫血,予静脉注射维生素B12肌肉注射,予口服叶酸对症。免疫球蛋白极度减低,予静注人免疫球蛋白补充丙种球蛋白对症。患儿维生素D缺乏,予骨化三醇口服补充,患儿低钾血症,予口服补钾。患儿病情好转,体重增长,予出院。出院医嘱建议每3周返院输注丙种球蛋白,并肌注维生素B12,定期复查血常规及网织红细胞情况。叶酸片(自备)每次0.5片、2次/d;骨化三醇胶丸每次1粒、1次/d。
患儿先后于2020年及2021年在本院就诊时的免疫功能检测结果见表1。CD19+B细胞比例一直极度低下,而免疫球蛋白的含量2021年与2020年相比,IgG降低1.8倍,IgM降低7倍,IgA降低5倍。静脉输注丙种球蛋白后,IgG含量迅速恢复至正常范围。

患儿免疫功能连续检测结果
患儿免疫功能连续检测结果
| 时间 | 2020年4月 | 2021年12月入院前 | 2022年1月治疗后 |
|---|---|---|---|
| CD3+(%) | 88.82 | 95.34 | / |
| CD3+CD8+(%) | 47.39 | 43.71 | / |
| CD3+CD4+(%) | 36.52 | 49.39 | / |
| CD4/CD8 | 0.77 | 1.13 | / |
| CD16+CD56+(%) | 10.63 | 4.41 | / |
| CD19+(%) | 0.06 | 0.04 | / |
| IgG(g/L) | 1.75 | 0.95 | 12.2 |
| IgM(g/L) | 0.14 | 0.02 | 0.06 |
| IgA(g/L) | 0.50 | 0.10 | 0.06 |
患儿出院后,未按时复查及输注丙种球蛋白,于2022年8月因咳嗽就诊,血常规3系已恢复正常,但红细胞平均体积提示为小细胞(MCV 67.9 fl),需考虑缺铁可能,但患儿拒绝进一步检查。
XLA是X染色体隐性遗传病,患者常为男性,XLA的发病率因国家而异,瑞士为1/200 000,西班牙1/20 000 000~1/10 000 000,挪威1/285 000~1/100 000,美国1/379 000,而国内尚未有XLA发病率的报道[4]。XLA患者易反复感染,且以细菌感染为主,以血清免疫球蛋白降低、B细胞缺如或降低为主要临床表现,通常在母源性抗体从婴儿体内消失后开始出现反复感染,即通常在6个月后开始出现症状,但也有报道称25%的XLA患者在4个月前会出现症状[5]。XLA一般起病年龄为9~18个月,但也有一些到成年甚至更晚才发病,国外研究报道,XLA的平均确诊年龄为26个月[6]。国内李瑛等[7]的研究报告显示其研究的20例XLA患儿基因确诊年龄为26~168个月龄,陆红宇[8]对23例XLA患儿的研究发现其确诊年龄为24~164个月龄。Chen等[4]对国内174名XLA患儿的统计发现,其发病年龄为(2.15±2.16)岁,中位数为1岁,平均诊断年龄为0.17~19岁。本例患儿出现症状时间为12个月龄左右,基因确诊的年龄为51个月龄,与国内报道的资料一致。
XLA最突出的临床表现是反复严重的细菌感染[9]。感染部位主要包括呼吸系统、消化系统及中枢神经系统,其中以呼吸道感染最为常见,常见病原菌包括流感嗜血杆菌、肺炎链球菌、金黄色葡萄球菌和假单胞菌属细菌等。消化道感染常见的症状有腹泻、腹痛、胃食管反流和胃肠炎。引起感染性腹泻的病原包括蓝氏贾第鞭毛虫、沙门菌、空肠弯曲菌、隐孢子虫等[10,11]。在其他的临床表现中,XLA患者容易出现中耳炎、慢性鼻窦炎、营养不良、贫血、粒细胞减少、血小板减少、自身免疫性疾病(类风湿性关节炎、皮肌炎等)、生长激素缺乏症及甲状腺激素紊乱等并发症状[9]。本例患儿初次在本院就诊原因为反复腹泻及生长缓慢就诊,在后期的检查中发现其生长激素缺乏,同时在大便中检出空肠弯曲菌及大肠杆菌EPEC菌株。由于长期腹泻,已出现低钾低磷血症,患儿后期由于外周血全血细胞减少再次入院,检查发现本例患儿为维生素B12缺乏的巨幼细胞贫血引起的外周血3系减少。由于患儿长期腹泻,因而考虑该患儿为维生素B12吸收障碍引起其缺乏而导致的巨幼细胞贫血。通常巨幼细胞贫血的发生是较缓慢的过程,患儿在此次入院8个月前,在门诊多次以反复上呼吸道感染就诊,期间虽未贫血但已出现大红细胞,但并未引起医生注意。对于维生素B12缺乏的巨幼细胞贫血的治疗,常为肌肉注射维生素B12,目前多以维生素B12一次肌注500~1000 μg[12]。对于任何由吸收不良引起的维生素B12缺乏,都应终身维持治疗,临床恢复后停用维生素B12治疗的患儿,神经症状一般在6个月内复发,巨幼细胞贫血在1年或数年后会再次出现[13]。
引起XLA的BTK基因定位于染色体Xq21.3-q22,属于胞质酪氨酸激酶有关的Tec家族成员,全长37.5 kb,含有19个外显子和PH区、TH区、SH3区、SH2区和TK区5个功能区,共有18个编码序列,编码全长为659个氨基酸的蛋白[14]。目前报道的BTK基因突变以错义突变最为多见,其次为移码突变、剪切突变和无义突变等[4]。目前BTK基因突变与临床严重度之间是否存在基因型-表型关系尚无明确定论,有研究显示有严重错义突变的患儿的发病时间及诊断时间较其他突变类型的患儿为早[15]。本例患儿突变位点为10号外显子c.894+2_894+3insT,属于剪切突变,变异来源为母亲。Chen等[4]也报道1例XLA患儿合并巨幼细胞贫血,其基因突变位点为2号外显子c.215G>A,为错义突变。两者突变位点不一样,本例患儿合并巨幼细胞贫血的原因可能与长期腹泻(导致维生素B12吸收不良)以及未按时输注免疫球蛋白有关,其中未按时输注免疫球蛋白可能导致长期消化道感染,以致肠道细菌异常过多,也会掠夺、消耗过多的维生素B12,使之吸收减少而致使巨幼细胞贫血的发生。
细胞及体液免疫功能检查是XLA诊断的关键之一,外周血CD19+B淋巴细胞计数显著降低以及血清中各类免疫球蛋白明显降低或缺乏是XLA的典型免疫学特征。患儿外周血中成熟B淋巴细胞减少或者缺乏,外周血CD19+B淋巴细胞计数显著降低,一般<2%。另外,淋巴结及淋巴组织缺乏生发中心和淋巴滤泡,骨髓中无浆细胞,但祖B细胞数量正常,T淋巴细胞数量及功能正常[16]。对于CD19+B淋巴细胞的百分比测定,WHO免疫缺陷病研究小组推荐使用流式细胞术进行检测,通过CD19的百分比衡量循环B淋巴细胞数量[17]。因此利用流式细胞术进行的淋巴细胞亚群检测对于XLA以及其他PID的早期筛查及诊断意义重大。而在免疫球蛋白含量上,XLA患儿的血清IgG水平降低通常<2 g/L,大部分XLA患儿血清IgG为1~2 g/L,少数患儿(<10%)的血清IgG可>2 g/L,而IgM和IgA水平通常<0.2 g/L。本例患儿初诊时由于其淋巴细胞亚群异常结果引起医生的关注,同时由于体液免疫的结果异常,临床高度怀疑免疫缺陷可能,随后行全外显子测序发现BTK基因突变,因而确诊患儿为XLA,但后期因患儿未规律治疗,免疫球蛋白含量甚至比以往更低,最终导致维生素B12缺乏的巨幼细胞贫血。
对于XLA患儿,主要治疗手段为静脉注射免疫球蛋白控制感染,当血清IgG维持5 g/L以上,感染明显减少,但有研究表明,此浓度不能提供足够保护,部分患儿可能需更高剂量的IgG以控制感染[18]。对于XLA患儿除了免疫球蛋白的输注以外,还应当注意营养的改善,避免由于营养物质缺乏或吸收障碍造成的贫血,例如缺铁性贫血或巨幼细胞性贫血。其中对于任何由吸收不良引起的维生素B12缺乏,都应终身维持治疗。
综上所述,XLA作为一种免疫缺陷病,淋巴细胞亚群的免疫分型及血清免疫球蛋白的检测对于XLA的早期筛查、诊断及疗效监控至关重要。早期干预治疗可显著提高患儿的生存质量,延长生存。
周百灵.X连锁无丙种球蛋白血症合并巨幼细胞贫血1例[DB/OL].中国临床案例成果数据库,2023(2023-04-23).http://journal.yiigle.com/LinkIn.do?linkin_type=cma&DOI=10.3760/cma.j.cmcr.2023.e01218.
所有作者均声明本研究不存在利益冲突